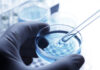
Микробиологический анализ питьевой воды: гарантия безопасности

Лидер группы «Ленинград» Сергей Шнуров сочинил ироничное стихотворение о неожиданной пользе российской вакцины от коронавируса. По мнению музыканта, единственным плюсом этого препарата для россиян станет вынужденный отказ от алкоголя.
Ранее стало известно, что вакцина от коронавируса несовместима со спиртными напитками. Шнуров считает, что испытать препарат от коронавируса захотят жители российских городов и деревень, школьники и студенты. И всех их, как подчеркнул лидер «Ленинграда» обратил внимание, не остановят никакие «кривотолки» о вакцине.
«Пусть будет она от ковида. А как не поможет? Да ну. Зато подошьете (аналог кодирования от алкоголизма. — Прим. ФАН) страну», — цитирует его URA.RU.
Напомним, российская вакцина стала первым в мире зарегистрированным препаратом от коронавируса. Она получила название «Спутник V» — в честь первого искусственного спутника Земли.
По словам главы Минздрава РФ Михаила Мурашко, спрос на российскую вакцину есть и в других странах мира, но за границу препарат пока не продают. Известно, что осенью «Спутник V» пройдет третьи клинические испытания на Филиппинах.